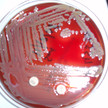
Elisabethkingia: Harmlos oder tödlich?

Thema: Risikomeldung/Rückruf
Artikel zum Thema
Infektionskrankheiten WHO: Zika gefährlicher als vermutet
Fünf Wochen nach Ausrufung eines globalen Gesundheitsnotstands wegen des Zika-Virus zieht die WHO eine erste Bilanz. Sie fällt alles andere als beruhigend aus.... Mehr»
AMK-Meldungen Pantoprazol Hennig muss zurück
Generikahersteller Hennig muss drei Medikamente zurückrufen. Unter anderem wurden beim Säureblocker Pantoprazol Fehler im Herstellungsprozess festgestellt, die... Mehr»
Infektionskrankheiten Elisabethkingia: Harmlos oder tödlich?
Seit November haben sich im US-Bundesstaat Wisconsin 44 Menschen mit dem Erreger Elisabethkingia anophelis infiziert und schwere Symptome gezeigt. 18 Patienten... Mehr»
AMK-Schnellinformation Kochsalz-Lösung: pH zu hoch
Berlin-Chemie ruft mit sofortiger Wirkung zwei Chargen seiner Natriumchlorid-Lösung zurück. Darüber informiert der Hersteller über die Arzneimittelkommission... Mehr»
Benzodiazepin-Überdosierungen sind in den USA für eine immer größere Zahl von Todesfällen verantwortlich. Das zeigt eine aktuelle Studie des Albert Einstein... Mehr»
Rote-Hand-Brief Verschärfte Vorsicht bei Myfortic
Novartis weist mit einem Rote-Hand-Brief auf wichtige Änderungen in der Fachinformation von Myfortic hin. Der Wirkstoff Mycophenolat-Natrium erhöht bei... Mehr»
AMK-Meldungen Tacrolimus Hexal: Zu viel Wirkstoff
Hexal ruft eine Charge des Immunsuppressivums Tacrolimus zurück. Bei Stabilitätsprüfungen wurde ein zu hoher Wirkstoffgehalt bei den Tabletten festgestellt. Ein... Mehr»
AMK-Meldungen Leber mit Lunge verwechselt
Die Firma Basics muss ihr Alzheimer-Mittel Donepezil zurückrufen. In der Gebrauchsinformation war das Wort „Lungenfunktionsstörungen“ mit... Mehr»
Antidiabetika SGLT2-Hemmer: Nutzen bestätigt
Das Nutzen-Risiko-Verhältnis für die Hemmer des natriumabhängigen Glukosetransporters Typ 2 (SGLT-2) bleibt positiv. Das meldet die Europäische... Mehr»
Medien zum Thema
- 1